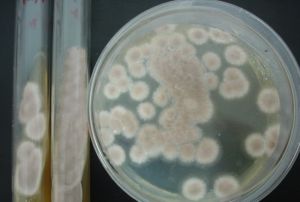
卵形巴貝斯蟲病

疾病簡介
卵形巴貝斯蟲病,是由卵形巴貝斯蟲引起的一種血液原蟲病,屬於寄生蟲病。
病原學
卵形巴貝斯蟲病蟲體形態具有多型性的特徵,呈卵形、圓形、出芽形、阿米巴形、單梨子形、雙梨子形及退化形,蟲體內有l~2個深紫色球形或不規則的染色質團,有時分布於蟲體邊緣,形成前端較寬的帶狀物質。蟲體的中央往往不著色,形成空泡,這種蟲體大多集中於血液塗片的末梢。球形核的外逸現象較常見,可觀察到正在外逸或NEJNIJ逸出的球形核,核逸出之後,蟲體呈現出上述的空泡。雙梨子形蟲體較寬大,一般大於紅細胞半徑,位於紅細胞中央,兩尖端成銳角或不相連。在疾病發展過程中,雙梨子形蟲體往往發生蛻變,變得窄而小,有時排列成鈍角,或兩尖端相連,頗像牛巴貝斯蟲。感染紅細胞一般寄生l~2個蟲體,個別可寄生4個。典型單梨子形和雙梨子形蟲體的大小範圍為2.3~3.9μm×2.1μm,平均為3.57μm×l.71μm。
流行病學
長角血蜱卵形巴貝斯蟲由長角血蜱經卵傳遞,次代幼蜱、若蜱、成蜱三個發育階段均可傳播病原,單一雄蟲也有傳播該種病原的能力。由於長角血蜱也是瑟氏泰勒蟲的媒介蜱,因而在自然界卵形巴貝斯蟲和瑟氏泰勒蟲常呈混合感染。
卵形巴貝斯蟲最早發現於日本,隨後報導於韓國。在我國最初分離自河南,貴州、吉林、甘肅等省也有報導。
臨床症狀
病畜本病的症狀和雙芽巴貝斯蟲病相似,主要表現體溫升高,精神沉鬱,食慾減退,流淚,腹瀉,消瘦,可視黏膜蒼白並有程度不等的黃疸,呼吸、脈搏加快,常有心律不齊,有的病牛有血尿。如呼吸困難、體溫下降時則預示死亡。
病理變化
牛屍僵完全,眼結膜微黃。胸部、後肢內側和下腹部水腫,皮下組織黃染明顯,血液稀薄凝固性較差。
心包積液,心內外膜有出血斑點,肝、腎腫大,。腎周脂肪膠樣水腫。脾質軟,脾髓紫紅,被膜出血。肺有小葉性肺炎灶。膀胱積暗紅色尿液,其黏膜出血。真胃黏膜潮紅,有出血點和潰瘍。小腸與大腸黏膜可見出血斑點。
疾病預防
牛體滅蜱:在春季和夏季蜱活動頻繁季節,每周對牛體噴灑或藥浴滅蜱一次。避蜱放牧:牛群應避免到蜱大量孳生和繁殖的牧場去放牧,以免受到蜱叮咬,必要時改為舍飼。
藥物預防:對疫區放牧的牛群,在發病季節到來前,每隔15天用三氮咪注射一次,劑量為每千克體重2毫克。也可以用咪唑苯脲預防效果更佳。